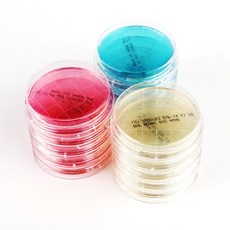
3d표면검사

오늘도 즐거운 하루 보내셨나요? {^_^}
자칭 IT전문가인 백설공쥬르 인사드립니다X3
오늘은
3d표면검사에 관해 분석해볼께요.
【3d표면검사 BEST인기순위 핵심 정보정리】
< 스토리 순서 >
① 언론기사 ② 노하우영상 ③ 마켓순위
☞ 3d표면검사 관련 최신 기사 확인하기 ☜
인텍플러스, 고급 완성차 생산라인에 면품질검사기 공급
LMI, 업계 최초 스마트 3D 라인 공초점 센서 출시
광학 기반 3D 측정 기술 개발사 ‘엠젠’, 글로벌 시장 진출 의지
☞ 관련 영상 ☜
☞ 구매랭킹 리스트 ☜
|

|
1위
마세라티 악기 lcd 패널 grancabrio granturismo 장착 대시보드 대형 화면 디지털 게이지 클러스터 android 6gb+128gb rom, 1-탄소 섬유
4,420,300원
[ 제품 및 후기보기 ]
|
|

|
3위
조도계 pc 탄소 섬유 3d 프린터 필라멘트 1.75mm1kg 인쇄 플라스틱 폴리 카보네이트 재료 높고 가벼운 무게 베스트 셀러, 플라스틱 탄소 섬유, 협력사
102,500원
[ 제품 및 후기보기 ]
|
|

|
4위
케이티알 표면검사/손검사용 키트 세균검사키트 (ST-25 PBS Swab Kit)
8,800원
[ 제품 및 후기보기 ]
|
|

|
5위
디에스스토리 표면 식중독균 검사키트 PDX-Salmonella(살모넬라) 10개 과학실험
52,800원
[ 제품 및 후기보기 ]
|
|
|
7위
생배지 로닥플레이트(Rodac Plate) 표면의 균 검사 50plates, 대장균(EMB)
98,000원
[ 제품 및 후기보기 ]
|
|

|
8위
ST-25 PBS Swab Kit 표면검사 키트 / 손검사용 키트 / 식품위생검사 키트 (인산완충식염수), 1팩 (10개)
9,000원
[ 제품 및 후기보기 ]
|
|

|
9위
3M 피펫스왑 Pipette Swab Stick 미생물검사 샘플채취 표면검사키트 Saline / BPW 10mlx10ea
17,000원
[ 제품 및 후기보기 ]
|
|

|
10위
디에스스토리 일회용 표면 검사용 채취틀 10x10cm 10개 과학실험키트
15,000원
[ 제품 및 후기보기 ]
|
|

|
11위
[루미테스터]전용시약/루시팩 펜/100EA/오염도검사/표면위생검사/식품위생모니터링/ATP축정기전용/도소매
385,000원
[ 제품 및 후기보기 ]
|
|

|
12위
게이지 포인트 투명 대비 PET 도트 비교 얼룩 균열 라인 표면 품질검사 필름 얼룩 카드, 투명 두께 0.1mm개
9,100원
[ 제품 및 후기보기 ]
|
|

|
16위
페인트 두께 측정기 표면 검사 철 아연 도금 알루미늄, ZL-T80 표준 제공
165,190원
[ 제품 및 후기보기 ]
|
|

|
17위
⊙♭한정판매◎ 표면검사 3M 학습교구 Kit 2팩 (tB*M†), Letits™ Saline(생리식염수-희석용)_Let™
50,140원
[ 제품 및 후기보기 ]
|
|

|
18위
디에스스토리 세균배양배지 만들기 세트 10인용-황색포도상구균(MSA) 과학실험
15,400원
[ 제품 및 후기보기 ]
|
|

|
19위
[풀리줄리] 슈퍼 다이체크 KD-RT 침투액 표면 균열 기공 틈 검사 경도양행 KD-PT 450ml
61,940원
[ 제품 및 후기보기 ]
|
|

|
20위
디에스스토리 1회용 표면 검사용 채취틀 10x10cm 10개 100개 과학실험키트
13,200원
[ 제품 및 후기보기 ]
|
주위 친구들이 실제 구입을 하고있는 3d표면검사 상품들의 목록을 만들어보았습니다.
제품정보, 가격 등은 항상 변동이 될 수 있다는 점 꼭 참고하시구요.
앞으로도 좋은 제품을 공유하기 위해 노력할께요~
행운이 가득한 하루 보내세요~^^
이 포스팅은 광고제휴활동으로서 일정 광고수수료를 수령할수 있습니다 .
|